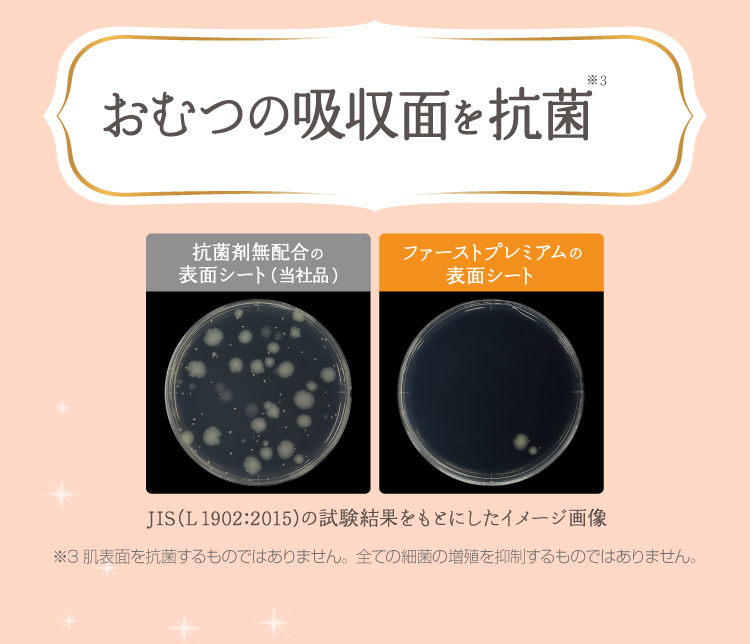

マイストア
変更
お店で受け取る
(送料無料)
配送する
納期目安:
2025.10.06 17:17頃のお届け予定です。
決済方法が、クレジット、代金引換の場合に限ります。その他の決済方法の場合はこちらをご確認ください。
※土・日・祝日の注文の場合や在庫状況によって、商品のお届けにお時間をいただく場合がございます。
ファーストプレミアムクリーム リセプトスキン プレミアムクリーム / ゼトックスタイルの詳細情報
リセプトスキン プレミアムクリーム / ゼトックスタイル。ゼトックスタイルオンラインショップ / リセプトスキン。メリーズ ファーストプレミアム 新生児用5000gまで 60枚。3つの新技術で目指せ-20歳肌!内容量30gから40gに増量しました!HNB:(Hydrogen in NanoBubble)1ccあたり4億個相当のナノバブルにマイクロクラスター由来の水素分子を閉じ込めています。PEM:(Penetration Emulsion Method)新たな乳化法を開発。 肌に負担なく、美容成分が深部まで届きます。保水力を高め、みずみずしい肌に導きます。【全成分表示】水、グリセリン、BG、ペンチレングリコール、PEG-75、セテアリルアルコール、ベヘニルアルコール、ベタイン、イソステアリン酸メチルヘプチル、スクワラン、プラセンタエキス、ヒアルロン酸Na、PCA-Na、セリン、グリシン、グルタミン酸、アラニン、アルギニン、リシン、アスパラギン酸、イソロイシン、トレオニン、バリン、フェニルアラニン、プロリン、オウゴン根エキス、オリーブ油、ステアリン酸グリセリル、(アクリレーツ/アクリル酸アルキル(C10-30))クロスポリマー、PEG-30フィトステロール、パラフィン、キャンデリラロウ、イソステアリン酸、ソルビトール、パルミトイルメチルタウリンNa、ジメチコン、ホウケイ酸(Ca/Na)、酸化銀、レブリン酸Na、アニス酸Na商品定価12000円。楽天市場】【エクスプレス便】First Aid Beauty Ultra Repair。肌トラブルの元、悪玉活性酸素に効果的に働きかけます。【GUERLAIN】 パリュール ゴールド スキン ダブル ヴェールプライマー。mama2 プロフお読み下さい様 化粧下地 コンシーラー。従来の特許技術より浸透性を強化。ゲラン パリュール ゴールド 24K プライマー。illun イリュン スキンベース。WKB:(Water Keep Barrier)最新のナノテクノロジーと独自技法で角質層の下に水分を留めることに成功。にっきちゃんサン専用YSL 2つ。クレ・ド・ポーボーテ ヴォワールコレクチュールn。 【ご使用方法】化粧水等の後、適量(パール粒大)を指先にとり、気になる部分を中心にお肌にやさしくなじませてください。SHISEIDO フューチャーソリューションLX ユニバーサル ディフェンスs
ベストセラーランキングです
近くの売り場の商品
カスタマーレビュー
オススメ度 4.5点
現在、2855件のレビューが投稿されています。